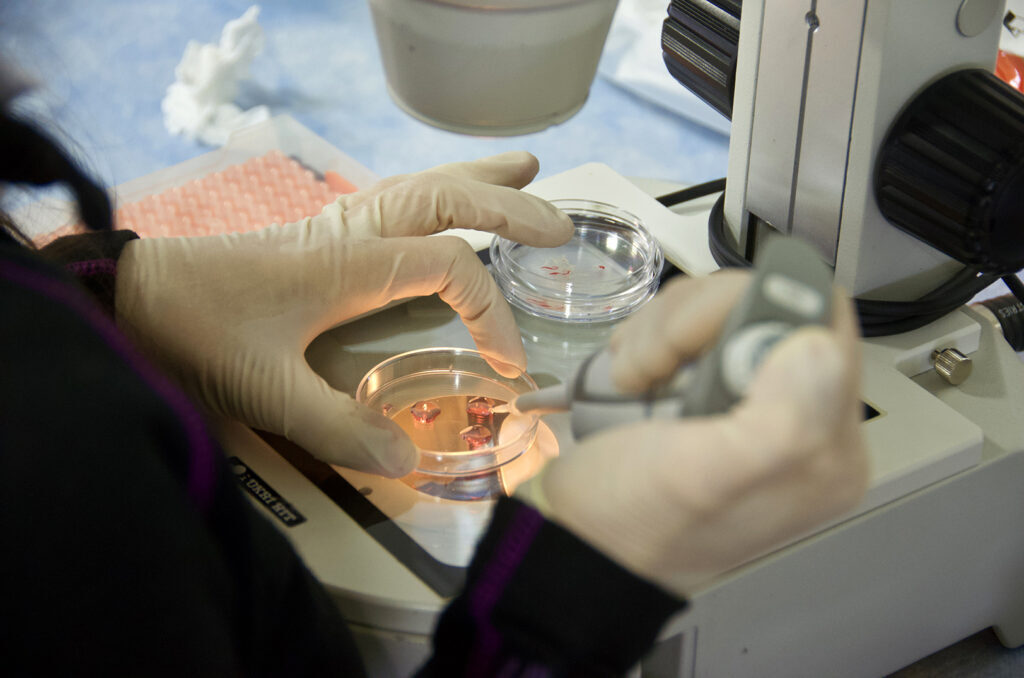

All Stories
Editor’s note: KCSourceLink and MOSourceLink are non-financial, community partners of Startland News. Missouri startups across the state created 40,169 jobs in 2022, according to the latest data, nearly matching the surge in the number of jobs they generated in 2021. Taking into consideration the number of employees these same firms hired in 2018 and in…
Read More >Vytelle expands hoofprint for its cattle IVF tech ‘closer to home,’ opening lab in Kearney, Nebraska
A new lab space for Kansas City-based Vytelle is expected to help the precision livestock startup increase regional accessibility to modern reproduction technology and enable the possibility of fresh embryo transfers for producers across the Midwest, said Kerryann Kocher. Vytelle — the fastest-growing in vitro fertilization (IVF) company — on Monday announced the opening of…
Read More >Launching a food business comes with unique challenges, Xander Winkel shared, and the Mid-Continent Public Library has partnered with several local organizations to help those specialized entrepreneurs find their recipe to success. The Food Business Conference — free workshops, panel discussions, and networking opportunities for “foodpreneurs” that are offered in partnership with the library, Kansas…
Read More >A history-making project on Ward Parkway — said to be the first minority-owned property on the storied Kansas City thoroughfare — already is demonstrating the power of unity amid divisive times, said Kim Randolph. Unveiled to the public Saturday, the new Minority Chamber of Commerce Development Center at 9100 Ward Parkway is now home to both…
Read More >Pipeline judges announced Megan O’Rear had the best pitch Thursday, but the Celerity Enterprises founder was left momentarily speechless when they named her winner of the group’s annual showcase and competition. “It just validates coming back to Kansas City,” said O’Rear, who also serves as the startup’s CEO. “Pipeline wants to help everybody that they…
Read More >Editor’s note: The Greater Kansas City Chamber of Commerce is a non-financial partner of Startland News, which serves as the media partner for the Small Business Superstars program. The Blueprint KC has come a long way, said Sheraz Pompey, emphasizing the meaningful impact of being showcased as one of the KC Chamber’s Small Business Superstars.…
Read More >Davids’ effort to level the playing field for Native entrepreneurs passes US House, moving to Senate
Legislation meant to address entrepreneurship challenges specific to Native and tribal business owners advanced in the U.S. Congress this week, with a Kansas City lawmaker championing the effort to bring equity to an overlooked corner of the small business community. “In Indian Country, Native-owned businesses employ over 300,000 Americans and are vital drivers of our…
Read More >A highly visible storefront along the KC Streetcar line is expected to give homegrown apparel brand Charlie Hustle a prime spot to showcase KC Heart for hundreds of thousands of potential shoppers during the coming Big 12 basketball tournament. The game day merch shop and experiential retail concept is expected to open Thursday, March 7…
Read More >A Kansas City marketing tech startup’s acquisition by Lytho, a leading creative project management platform, is built upon the two brands’ complementary company ideologies and tech, said Brock Stechman. “We’re seeing a lot of consolidation in our market, and this was an opportunity where we could collaborate and come together seamlessly with a single, specialized,…
Read More >